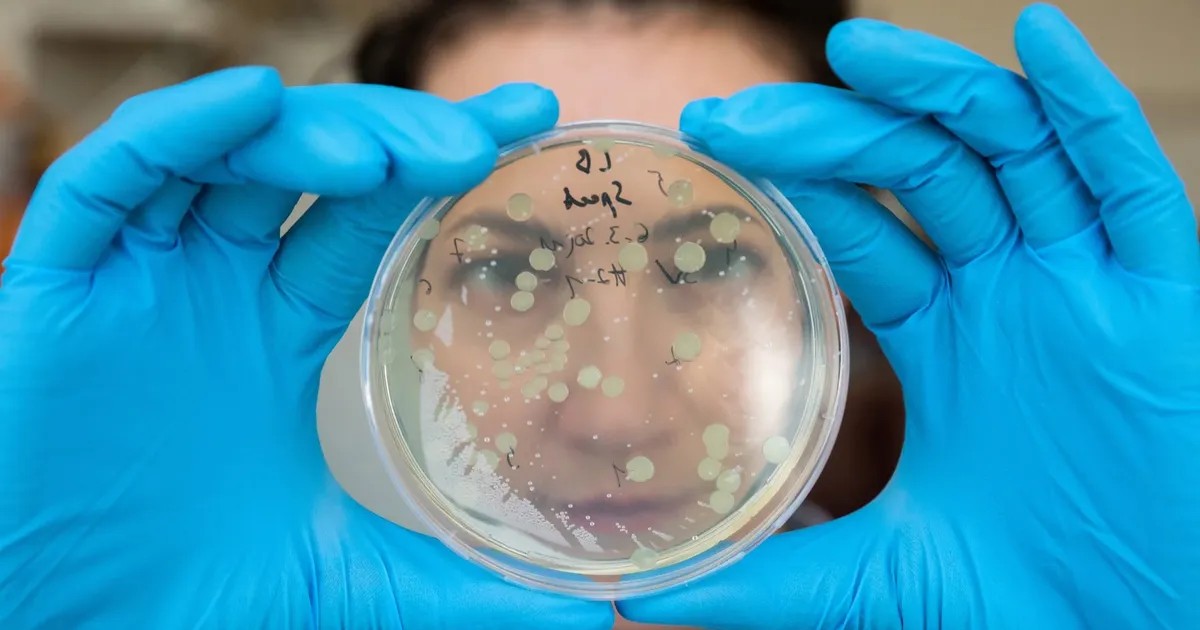
Откройте секреты своей ДНК: как тестирование может раскрыть ваши королевские корни

Дети на связи: как обрабатываются вызовы несовершеннолетних в Службу 112 Москвы
2025-03-25
Рамблер/женский
Звонок, ответ оператора, детский голос в трубке... Вызовы от детей в Службу 112 Москвы не редкость. Некоторые из них являются баловством, однако нередко девочкам и мальчикам действительно нужна помощь. Служба 112 Москвы готова помочь в любой ситуации, будь то реальная угроза или просто детская шалость. Операторы всегда готовы выслушать и принять необходимые меры. Служба 112 - это гарантия безопасности и помощи для всех, включая детей. Вызывая 112, дети могут получить помощь в экстренных ситуациях, таких как пожар, медицинская помощь или другие чрезвычайные ситуации.